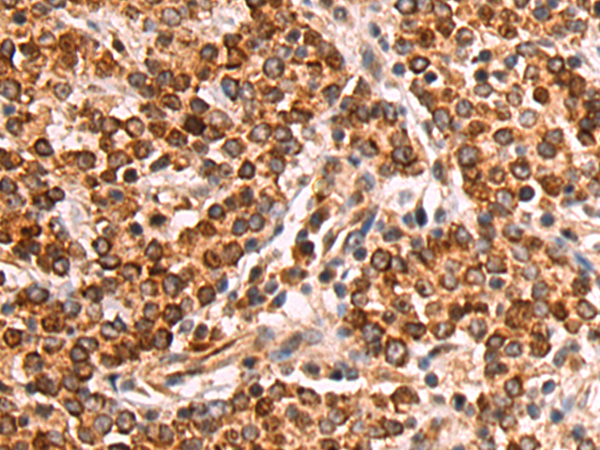

-
分类: 科研抗体货号: P03554别名: MYP25应用: IHC反应种属: Human, Mouse
-
分类: 科研抗体货号: P03565别名: CT74; LELA1; CCDC36应用: IHC反应种属: Human
-
分类: 科研抗体货号: P03546别名:应用: IHC反应种属: Human, Mouse, Rat
-
分类: 科研抗体货号: P03622别名: POR应用: IHC反应种属: Human, Mouse, Rat
-
分类: 科研抗体货号: P03544别名: PCL1应用: WB,IHC反应种属: Human
-
分类: 科研抗体货号: P03617别名: CREST; LP2261应用: WB反应种属: Human, Mouse, Rat
-
分类: 科研抗体货号: P03541别名: ZASC1; ANC-2H01; ANC_2H01应用: WB,IHC反应种属: Human, Mouse, Rat
-
分类: 科研抗体货号: P03616别名: RRIG1; PP6569; PP9455应用: IHC反应种属: Human, Mouse, Rat
-
分类: 科研抗体货号: P03536别名: FMO1B1应用: IHC反应种属: Human, Mouse, Rat
-
分类: 科研抗体货号: P03615别名:应用: IHC反应种属: Human, Mouse

鄂公网安备42018502007531号
鄂公网安备42018502007531号

